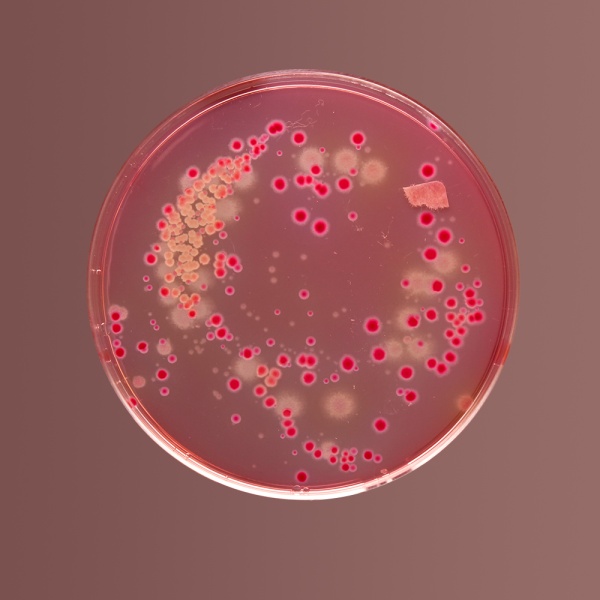

Produits de la boutique 
Veuillez vous connecter à votre compte en ligne pour afficher vos tarifs réduits
Catalog No: CG-GM971-500G
On Request
Catalog No: CG-GM976-500G
On Request
Catalog No: CG-GMH011-500G
On Request
Catalog No: CG-GMH011G-500G
On Request

Filtre
Filtre